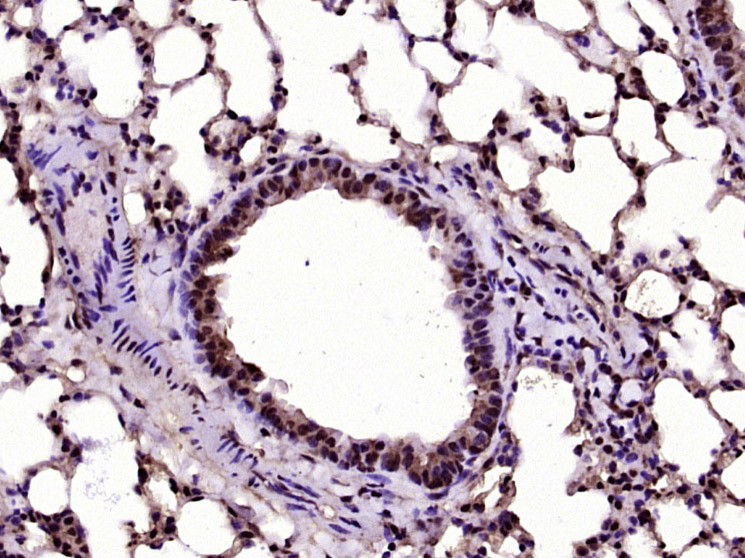
phospho-AKT1 (Ser129) Rabbit p

相关产品推荐更多 >
万千商家帮你免费找货
0 人在求购买到急需产品
- 详细信息
- 文献和实验
- 技术资料
- 应用范围:
产品信息以Bioss网站为准
- 规格:
50ul/100ul/200ul
| 规格: | 50ul | 产品价格: | ¥1180.0 |
|---|---|---|---|
| 规格: | 100ul | 产品价格: | ¥1980.0 |
| 规格: | 200ul | 产品价格: | ¥2800.0 |
| 产品编号 | bs-5188R |
| 英文名称 | phospho-AKT1 (Ser129) Rabbit pAb |
| 中文名称 | 磷酸化蛋白激酶B抗体 |
| 英文别名 | AKT1(phospho Ser129); p-AKT1(phospho S129); AKT 1; AKT; AKT1; AKT-1; AKT1_HUMAN; C AKT; cAKT; MGC9965; MGC99656; Oncogene AKT1; PKB; PKB alpha; PKB-ALPHA; PRKBA; Protein Kinase B alpha; Protein kinase B; Proto-oncogene c-Akt; RAC alpha; RAC alpha serine/threonine protein kinase; RAC; RAC PK alpha; Rac protein kinase alpha; RAC Serine/Threonine Protein Kinase; RAC-alpha serine/threonine-protein kinase; RAC-PK-alpha; v akt murine thymoma viral oncogene homolog 1; vAKT Murine Thymoma Viral Oncogene Homolog 1. |
| 产品应用 | WB=1:500-2000, IHC-P=1:100-500, IHC-F=1:100-500, IF=1:100-500, Flow-Cyt=2ug/Test Not yet tested in other applications. |
| 交叉反应 | Human, Mouse, Rat (Chicken, Dog, Horse) |
| 抗体来源 | Rabbit |
| 免疫原 | KLH conjugated Synthesised phosphopeptide derived from human Akt1 around the phosphorylation site of Ser129 |
| 亚型 | IgG |
| 性状 | Liquid |
| 纯化方法 | affinity purified by Protein A |
| 克隆类型 | Polyclonal |
| 理论分子量 | 56 kDa |
| 浓度 | 1mg/ml |
| 储存液 | 0.01M TBS (pH7.4) with 1% BSA, 0.02% Proclin300 and 50% Glycerol. |
| 研究领域 | Cancer > Cell Death > Apoptosis > Metabolism Cancer > Signal transduction > Protein phosphorylation > Serine/threonine kinases > AKT Epigenetics and Nuclear Signaling > Cell cycle > Apoptosis > Nuclear Metabolism > Pathways and Processes > Metabolism processes > Apoptosis Signal Transduction > Protein Phosphorylation > Ser / Thr Kinases > PKB / AKT |
| 亚基 | Interacts (via the C-terminus) with CCDC88A (via its C-terminus). Interacts with GRB10; the interaction leads to GRB10 phosphorylation thus promoting YWHAE-binding. Interacts with AGAP2 (isoform 2/PIKE-A); the interaction occurs in the presence of guanine nucleotides. Interacts with AKTIP. Interacts (via PH domain) with MTCP1, TCL1A AND TCL1B. Interacts with CDKN1B; the interaction phosphorylates CDKN1B promoting 14-3-3 binding and cell-cycle progression. Interacts with MAP3K5 and TRAF6. Interacts with BAD, PPP2R5B, STK3 and STK4. Interacts (via PH domain) with SIRT1. Interacts with SRPK2 in a phosphorylation-dependent manner. Interacts with RAF1. Interacts with TRIM13; the interaction ubiquitinates AKT1 leading to its proteasomal degradation. Interacts with TNK2 and CLK2. Interacts (via the C-terminus) with THEM4 (via its C-terminus). Interacts with and phosphorylated by PDPK1. |
| 亚细胞定位 | Cytoplasm. Nucleus. Cell membrane. Note=Nucleus after activation by integrin-linked protein kinase 1 (ILK1). Nuclear translocation is enhanced by interaction with TCL1A. Phosphorylation on Tyr-176 by TNK2 results in its localization to the cell membrane where it is targeted for further phosphorylations on Thr-308 and Ser-473 leading to its activation and the activated form translocates to the nucleus. |
| 组织特异性 | Expressed in prostate cancer and levels increase from the normal to the malignant state (at protein level). Expressed in all human cell types so far analyzed. The Tyr-176 phosphorylated form shows a significant increase in expression in breast cancers during the progressive stages i.e. normal to hyperplasia (ADH), ductal carcinoma in situ (DCIS), invasive ductal carcinoma (IDC) and lymph node metastatic (LNMM) stages. |
| 翻译后修饰 | O-GlcNAcylation at Thr-305 and Thr-312 inhibits activating phosphorylation at Thr-308 via disrupting the interaction between AKT1 and PDPK1. O-GlcNAcylation at Ser-473 also probably interferes with phosphorylation at this site. Phosphorylation on Thr-308, Ser-473 and Tyr-474 is required for full activity. Activated TNK2 phosphorylates it on Tyr-176 resulting in its binding to the anionic plasma membrane phospholipid PA. This phosphorylated form localizes to the cell membrane, where it is targeted by PDPK1 and PDPK2 for further phosphorylations on Thr-308 and Ser-473 leading to its activation. Ser-473 phosphorylation by mTORC2 favors Thr-308 phosphorylation by PDPK1. Ser-473 phosphorylation is enhanced by interaction with AGAP2 isoform 2 (PIKE-A). Ser-473 phosphorylation is enhanced in focal cortical dysplasias with Taylor-type balloon cells. Ser-473 phosphorylation is enhanced by signaling through activated FLT3. Dephosphorylated at Thr-308 and Ser-473 by PP2A phosphatase. The phosphorylated form of PPP2R5B is required for bridging AKT1 with PP2A phosphatase. Ubiquitinated via 'Lys-48'-linked polyubiquitination by ZNRF1, leading to its degradation by the proteasome. Ubiquitinated; undergoes both 'Lys-48'- and 'Lys-63'-linked polyubiquitination. TRAF6-induced 'Lys-63'-linked AKT1 ubiquitination is critical for phosphorylation and activation. When ubiquitinated, it translocates to the plasma membrane, where it becomes phosphorylated. When fully phosphorylated and translocated into the nucleus, undergoes 'Lys-48'-polyubiquitination catalyzed by TTC3, leading to its degradation by the proteasome. Also ubiquitinated by TRIM13 leading to its proteasomal degradation. Acetylated on Lys-14 and Lys-20 by the histone acetyltransferases EP300 and KAT2B. Acetylation results in reduced phosphorylation and inhibition of activity. Deacetylated at Lys-14 and Lys-20 by SIRT1. SIRT1-mediated deacetylation relieves the inhibition. |
| 相似性 | Belongs to the protein kinase superfamily. AGC Ser/Thr protein kinase family. RAC subfamily. Contains 1 AGC-kinase C-terminal domain. Contains 1 PH domain. Contains 1 protein kinase domain. |
| 功能 | AKT1 is one of 3 closely related serine/threonine-protein kinases (AKT1, AKT2 and AKT3) called the AKT kinase, and which regulate many processes including metabolism, proliferation, cell survival, growth and angiogenesis. This is mediated through serine and/or threonine phosphorylation of a range of downstream substrates. Over 100 substrate candidates have been reported so far, but for most of them, no isoform specificity has been reported. AKT is responsible of the regulation of glucose uptake by mediating insulin-induced translocation of the SLC2A4/GLUT4 glucose transporter to the cell surface. Phosphorylation of PTPN1 at 'Ser-50' negatively modulates its phosphatase activity preventing dephosphorylation of the insulin receptor and the attenuation of insulin signaling. Phosphorylation of TBC1D4 triggers the binding of this effector to inhibitory 14-3-3 proteins, which is required for insulin-stimulated glucose transport. AKT regulates also the storage of glucose in the form of glycogen by phosphorylating GSK3A at 'Ser-21' and GSK3B at 'Ser-9', resulting in inhibition of its kinase activity. Phosphorylation of GSK3 isoforms by AKT is also thought to be one mechanism by which cell proliferation is driven. AKT regulates also cell survival via the phosphorylation of MAP3K5 (apoptosis signal-related kinase). Phosphorylation of 'Ser-83' decreases MAP3K5 kinase activity stimulated by oxidative stress and thereby prevents apoptosis. AKT mediates insulin-stimulated protein synthesis by phosphorylating TSC2 at 'Ser-939' and 'Thr-1462', thereby activating mTORC1 signaling and leading to both phosphorylation of 4E-BP1 and in activation of RPS6KB1. AKT is involved in the phosphorylation of members of the FOXO factors (Forkhead family of transcription factors), leading to binding of 14-3-3 proteins and cytoplasmic localization. In particular, FOXO1 is phosphorylated at 'Thr-24', 'Ser-256' and 'Ser-319'. FOXO3 and FOXO4 are phosphorylated on equivalent sites. AKT has an important role in the regulation of NF-kappa-B-dependent gene transcription and positively regulates the activity of CREB1 (cyclic AMP (cAMP)-response element binding protein). The phosphorylation of CREB1 induces the binding of accessory proteins that are necessary for the transcription of pro-survival genes such as BCL2 and MCL1. AKT phosphorylates 'Ser-454' on ATP citrate lyase (ACLY), thereby potentially regulating ACLY activity and fatty acid synthesis. Activates the 3B isoform of cyclic nucleotide phosphodiesterase (PDE3B) via phosphorylation of 'Ser-273', resulting in reduced cyclic AMP levels and inhibition of lipolysis. Phosphorylates PIKFYVE on 'Ser-318', which results in increased PI(3)P-5 activity. The Rho GTPase-activating protein DLC1 is another substrate and its phosphorylation is implicated in the regulation cell proliferation and cell growth. AKT plays a role as key modulator of the AKT-mTOR signaling pathway controlling the tempo of the process of newborn neurons integration during adult neurogenesis, including correct neuron positioning, dendritic development and synapse formation. Signals downstream of phosphatidylinositol 3-kinase (PI(3)K) to mediate the effects of various growth factors such as platelet-derived growth factor (PDGF), epidermal growth factor (EGF), insulin and insulin-like growth factor I (IGF-I). AKT mediates the antiapoptotic effects of IGF-I. Essential for the SPATA13-mediated regulation of cell migration and adhesion assembly and disassembly. May be involved in the regulation of the placental development. Phosphorylates STK4/MST1 at 'Thr-120' and 'Thr-387' leading to inhibition of its: kinase activity, nuclear translocation, autophosphorylation and ability to phosphorylate FOXO3. Phosphorylates STK3/MST2 at 'Thr-117' and 'Thr-384' leading to inhibition of its: cleavage, kinase activity, autophosphorylation at Thr-180, binding to RASSF1 and nuclear translocation. Phosphorylates SRPK2 and enhances its kinase activity towards SRSF2 and ACIN1 and promotes its nuclear translocation. Phosphorylates RAF1 at 'Ser-259' and negatively regulates its activity. Phosphorylation of BAD stimulates its pro-apoptotic activity. |
| 保存条件 | Shipped at 4℃. Store at -20℃ for one year. Avoid repeated freeze/thaw cycles. |
| 注意事项 | This product as supplied is intended for research use only, not for use in human, therapeutic or diagnostic applications. |
| 背景资料 | This gene encodes one of the three members of the human AKT serine-threonine protein kinase family which are often referred to as protein kinase B alpha, beta, and gamma. These highly similar AKT proteins all have an N-terminal pleckstrin homology domain, a serine/threonine-specific kinase domain and a C-terminal regulatory domain. These proteins are phosphorylated by phosphoinositide 3-kinase (PI3K). AKT/PI3K forms a key component of many signalling pathways that involve the binding of membrane-bound ligands such as receptor tyrosine kinases, G-protein coupled receptors, and integrin-linked kinase. These AKT proteins therefore regulate a wide variety of cellular functions including cell proliferation, survival, metabolism, and angiogenesis in both normal and malignant cells. AKT proteins are recruited to the cell membrane by phosphatidylinositol 3,4,5-trisphosphate (PIP3) after phosphorylation of phosphatidylinositol 4,5-bisphosphate (PIP2) by PI3K. Subsequent phosphorylation of both threonine residue 308 and serine residue 473 is required for full activation of the AKT1 protein encoded by this gene. Phosphorylation of additional residues also occurs, for example, in response to insulin growth factor-1 and epidermal growth factor. Protein phosphatases act as negative regulators of AKT proteins by dephosphorylating AKT or PIP3. The PI3K/AKT signalling pathway is crucial for tumor cell survival. Survival factors can suppress apoptosis in a transcription-independent manner by activating AKT1 which then phosphorylates and inactivates components of the apoptotic machinery. AKT proteins also participate in the mammalian target of rapamycin (mTOR) signalling pathway which controls the assembly of the eukaryotic translation initiation factor 4F (eIF4E) complex and this pathway, in addition to responding to extracellular signals from growth factors and cytokines, is disregulated in many cancers. Mutations in this gene are associated with multiple types of cancer and excessive tissue growth including Proteus syndrome and Cowden syndrome 6, and breast, colorectal, and ovarian cancers. Multiple alternatively spliced transcript variants have been found for this gene. [provided by RefSeq, Jul 2020] |
| 应用 | 推荐稀释比例 |
| {WB} | {1:500-2000} |
| {IHC-P} | {1:100-500} |
| {IHC-F} | {1:100-500} |
| {IF} | {1:100-500} |
| {Flow-Cyt} | {2ug/Test} |

Primary Antibody (green line): Rabbit Anti-phospho-AKT1 (Ser129) antibody (bs-5188R)
Dilution: 2μg /10^6 cells;
Isotype Control Antibody (orange line): Rabbit IgG .
Secondary Antibody : Goat anti-rabbit IgG-FITC
Dilution: 1μg /test.
Protocol
The cells were incubated in 5%BSA to block non-specific protein-protein interactions for 30 min at room temperature .Cells stained with Primary Antibody for 30 min at room temperature. The secondary antibody used for 40 min at room temperature. Acquisition of 20,000 events was performed.


风险提示:丁香通仅作为第三方平台,为商家信息发布提供平台空间。用户咨询产品时请注意保护个人信息及财产安全,合理判断,谨慎选购商品,商家和用户对交易行为负责。对于医疗器械类产品,请先查证核实企业经营资质和医疗器械产品注册证情况。
文献和实验[IF={{ 2.682 }}] {Deng Yang-lin. et al. Prescription of Sageretia hamosa Brongn Relieved Goiter through Promoted Apoptosis of Thyroid Cells via miR-511-3p and PTEN/PI3K/Akt Pathway. J Healthc Eng. 2021;2021:3506559} {WB} {Rat,Human}
:使用 Anti-phospho-Akt (Ser473) Rabbit mAb 对石蜡包埋的人乳腺癌组织进行免疫组织化学分析。(图 A)使用免疫组化试剂盒M&R HRP/DAB Detection IHC Kit,抗体 1:100 稀释;(图 B) 采用普通免疫组化试剂盒,抗体 1:25 稀释。 图 6 免疫组化实验检测 Erk1/2 表达 注:使用 Anti-Erk1/2 Mouse mAb与p44/42 MAPK (Erk1/2)Rabbit mAb 对正常小鼠心脏组织进行免疫
at 10, 25, and 50 μM). At 24 h post-treatment, celllysates were obtained; SDS-PAGE and Western blotting were performed as described in Section 3, Methods. AR-A014418dose-dependent decreases of phospho-β-catenin (Ser33/37) and phospho-glycogen synthase
(Ser473)(193H12)Rabbit mAb,1:300,稀释,二抗是驴抗兔,1:2000,我是实验室的新手,刚呆俩月,受 此挫折,一头雾水,请过来人或者有经验的同学帮忙解答怎样解决,非常感谢! 碧峤 pAkt有两个位点,Ser473和Thr308,其中Ser473相对容易显色。如果显色失败,可能的原因:1 上样量过少,我们一般都是30μg;2 一抗孵育时间过短,我们一般24h~48h;3 一抗是否工作有待排除 米宝
技术资料暂无技术资料 索取技术资料









